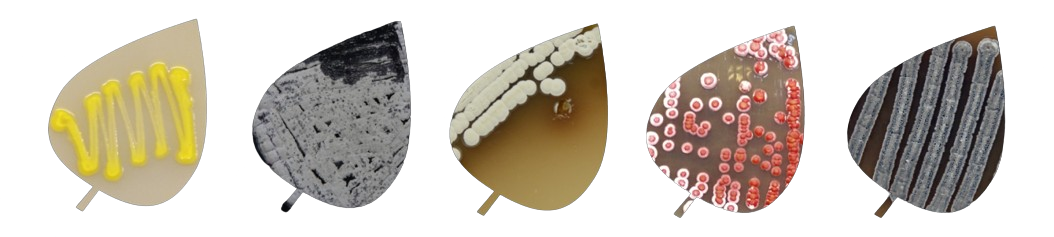
WoldsWithinWorlds-Banner-transparent

U prvom izdanju programa Art meets Science, organizacija Re:people je u saradnji sa IMGGI približila publici svet biopigmenata. Na poziv da doprinesu ovom jednogodišnjem interdisciplinarnom projektu, umetnici Emir Šehanović, Emilija Radojičić, Jovana Čavorović, Dragana Lukić i Sonja Lundin radili su sa timom iz IMGGI, istražujući nove pristupe inovativnim izazovima u oblasti ekološkog vajanja, tkanja, umetničke instalacije i grafike.
Projekat je rezultirao dvema izložbama – u Muzeju primenjene umetnosti u Beogradu i Fondaciji Petrović u Crnoj Gori, vođenim turama, kao i retrospektivnom panel-diskusijom u co-working habu Nova Iskra, u partnerstvu sa platformom MADE IN.


„U savremenom diskursu o umetnosti, ‘pigment’ se može klasifikovati pomoću različitih praktičnih nomenklatura, kao što su RGB, CMYK i druge. Ipak, ‘pigment’ ima višeslojno značenje, a osnova njegovih opažljivih karakteristika ne može se ni precizno definisati ni reprodukovati.
Izložba Neka druga mesta ne ograničava se na distanciranu, naučnu perspektivu, već se bavi ličnim i emocionalnim odnosom koji proističe iz samog porekla, filtriranog kroz eksperiment, dok njegovo nasleđe i topografski ostaci života postaju u fokusu umetničkog istraživanja. Kolonizovani mikroorganizmi, prikupljeni iz različitih prirodnih izvora, omogućavaju ekonomske i tehnološke prednosti zamenom veštačkih pigmenata organskim i smanjenjem količine otpada koji se ispušta u vodu. Kao takav, čitav koncept projekta razmatra pitanje uticaja — konkretno uticaja prirodnog nasleđa — kao načina razmišljanja i povezivanja kroz kulturnu praksu, slično načinu na koji nas posmatranje i sećanje oblikuju.“
Ivan Šuković

Izložba „Neka druga mesta“ privukla je značajnu pažnju profesionalne, umetničke i šire publike u Srbiji. Više od 40 nacionalnih i specijalizovanih medija, kako elektronskih, tako i štampanih, obradilo je ovaj naučno-umetnički projekat.
Zapaženi medijski nastupi imali su suosnivač i programski direktor Re:people, Branka Anđelković, kustos i umetnički direktor Re:people, Ivan Šuković, i umetnica i koordinator projekta, Sonja Lundin.
RTS Nauka – „RTS Lab: TEHNO I ART“ – 25.10.2023.

Projekat AMS iz 2023. godine proširio je svoj domet sve do Crne Gore, čineći međunarodnu prezentaciju saradnje između IMGGI, Re:people centra i gostujućih umetnika u Fondaciji Petrović Njegoš u Podgorici. Na promociji događaja učestvovali su kustos Ivan Šuković, umetnica Dragana Lukić i hemičarka Jelena Lazić.

Održan u prostoru za saradnju Nova Iskra, Dorćol, u partnerstvu sa platformom MADE IN, ovaj okrugli sto okupio je umetnike AMS projekta i hemičarku Jelenu Lazić, zajedno sa gostujućom umetnicom Milicom Lazarević, kako bi podelili svoja iskustva u radu sa bio-pigmentima.
Kako definišemo inovativno umetničko delo u odnosu na inovativnu tehnologiju? Gde se nalazi granica između interdisciplinarne saradnje i tehničkog savetovanja? Šta budućnost donosi umetnosti i nauci — zajedno? Ova i brojna druga pitanja postavljena su našim kolegama kako bismo dublje istražili savremenu umetničku scenu i njeno prožimanje sa naukom.






